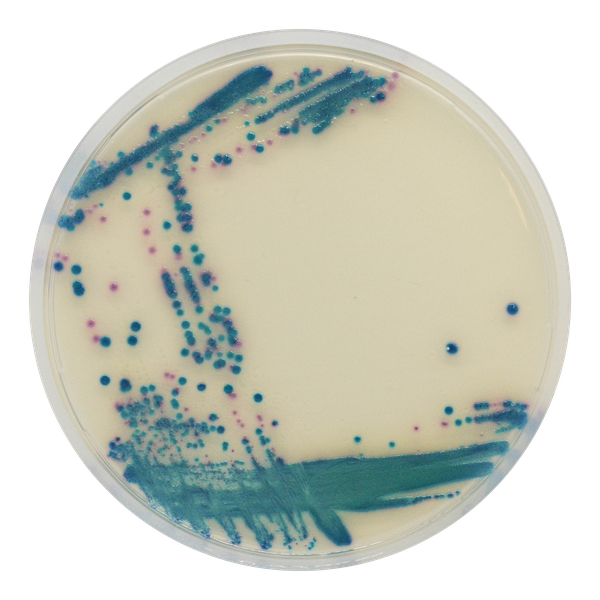
CHROMagar™ ESBL
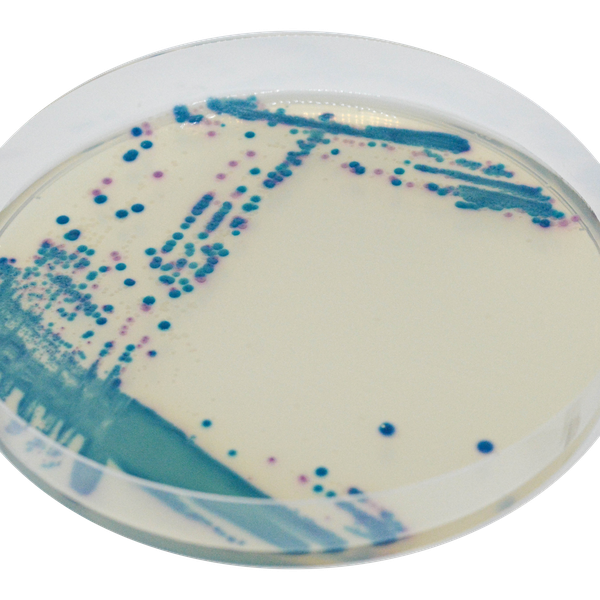
CHROMagar™ ESBL

Hình thái khuẩn lạc

E. coli ESBL
hồng đậm đến đỏ

Klebsiella, Enterobacter,
Citrobacter ESBL

Proteus ESBL
hạo quang nâu

Pseudomonas ESBL
kem mờ đến xanh dương

Acinetobacter ESBL
kem, đục
Hiệu năng
Hiệu năng
ESBL (Extended Spectrum β-Lactamases) là những enzyme làm trung gian kháng lại penicillin, cephalosporin thế hệ ba phổ rộng (C3G) và monobactam. Enterobacteriaceae sản xuất ESBL bắt đầu xuất hiện từ những năm 1980, và từ đó đã trở thành một trong những nhiễm trùng bệnh viện quan trọng nhất với Escherichia coli và Klebsiella spp. là các tác nhân chính, nhưng cũng có sự xuất hiện của các loài Gram âm khác. Sự xuất hiện của các chủng sản xuất ESBL có những ảnh hưởng lâm sàng và điều trị quan trọng:
- Các yếu tố kháng đối với sản xuất ESBL được mang trên plasmid có thể dễ dàng lây lan từ vi sinh vật này sang vi sinh vật khác.
- Sự lan rộng của kháng đối với cephalosporin rộng có thể dẫn đến tăng sử dụng các loại thuốc rộng và đắt hơn.
- Những chủng kháng này có thể thoát khỏi phát hiện với xét nghiệm nhạy thường quy được thực hiện bởi phòng xét nghiệm vi sinh lâm sàng, điều này có thể dẫn đến kết quả điều trị không tốt.
Do đó, phát hiện sớm vi khuẩn mang ESBL là quan trọng để giảm thiểu ảnh hưởng của chúng và ngăn ngừa sự lây lan của nhiễm trùng và tùy chỉnh điều trị bệnh nhân.
CHROMagar™ ESBL cho phép phát hiện vi khuẩn sản xuất ESBL trong khi ức chế sự phát triển của các vi khuẩn khác, bao gồm hầu hết những vi khuẩn mang kháng AmpC. Đây là một đặc điểm quan trọng vì kháng AmpC nội tại có ít liên quan dịch tễ học hơn, nhưng thường dẫn đến kết quả dương tính giả ESBL trong các phương pháp kiểm tra cổ điển.
Mục đích sử dụng :
CHROMagar™ ESBL là môi trường nuôi cấy chromogen chọn lọc và phân biệt, được dùng để phát hiện trực tiếp định tính tình trạng mang vi khuẩn kháng beta-lactamase phổ rộng (ESBL) tại đường tiêu hóa nhằm hỗ trợ phòng ngừa và kiểm soát ESBL trong các cơ sở chăm sóc sức khỏe. Thử nghiệm được thực hiện với mẫu gạc trực tràng và phân từ bệnh nhân để sàng lọc tình trạng mang ESBL. Kết quả có thể được diễn giải sau 18-24 giờ ủ hiếu khí ở 35-37 °C.
Môi trường này cũng có thể được sử dụng như chỉ báo cảnh báo sớm cho các xét nghiệm chẩn đoán nhiễm trùng để báo hiệu sự có mặt có thể của vi khuẩn kháng nhiều thuốc. Việc sử dụng này không thay thế các giao thức của cơ sở.
CHROMagar™ ESBL không nhằm chẩn đoán nhiễm trùng do các chủng sản xuất ESBL, cũng không hướng dẫn hay theo dõi điều trị nhiễm trùng. Sự thiếu phát triển hoặc không có khuẩn lạc trên CHROMagar™ ESBL không loại trừ sự có mặt của vi khuẩn sản xuất ESBL. Cần thêm xét nghiệm nhận dạng, kiểm tra nhạy kháng, và định typ dịch tễ học trên các khuẩn lạc nghi ngờ.
1. Kết quả nhanh: Phát hiện sau ủ qua đêm.
4. Tiết kiệm thời gian và công việc: Nuôi cấy trực tiếp từ mẫu. Không cần phải làm giàu chọn lọc trước.
2. Phân biệt loài nhờ hiệu năng chromogenic của CHROMagar™ Orientation đã bổ sung. Thực tế, sản phẩm bao gồm một bột nền CHROMagar™ Orientation và một chất bổ sung để tăng cường các vi khuẩn sản xuất ESBL.
5. Linh hoạt: CHROMagar™ ESBL được cung cấp với thời hạn sử dụng hơn 18 tháng. Điều này cho phép sự linh hoạt trong việc sử dụng, dù trong tình huống dịch tễ với nhiều bệnh nhân cần sàng lọc, hay trong giám sát ngẫu nhiên các nuôi cấy.
 <img src="/Data-EN-3-1754042229-1772077946.png" width="1016" height="580" alt="" title="Data EN" />
<img src="/Data-EN-3-1754042229-1772077946.png" width="1016" height="580" alt="" title="Data EN" />

Xem thêm